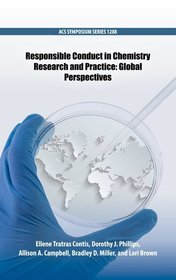
Responsible Conduct in Chemistry Research and Practice: Global Perspectives

The Posthumous Nobel Prize in Chemistry: Ladies in Waiting for the Nobel Prize (Volume 2)
56 135 Ft
50 522 Ft

Hispanic Foods: Chemistry and Bioactive Compounds
77 634 Ft
69 870 Ft

Pest Management with Natural Products
77 634 Ft
69 870 Ft

Synthesis and Chemistry of Agrochemicals Series VIII
35 353 Ft
31 818 Ft

Building and Maintaining Award-Winning ACS Student Members Chapters Volume 3
56 135 Ft
50 522 Ft

Advances in CO2 Conversion and Utilization
77 634 Ft
69 870 Ft

Flavors in Noncarbonated Beverages
82 411 Ft
74 170 Ft

Stereochemistry and Global Connectivity: The Legacy of Ernest L. Eliel Volume 1
56 135 Ft
50 522 Ft

Building and Maintaining Award-Winning ACS Student Member Chapters Volume 1: Holistic Viewpoints
68 079 Ft
61 271 Ft

Building and Maintaining Award-Winning ACS Student Member Chapters Volume 2: Specific Program Areas
68 079 Ft
61 271 Ft

Trajectories of Chemistry Education Innovation and Reform
77 634 Ft
69 870 Ft

Advances in Applied Nanotechnology for Agriculture
77 634 Ft
69 870 Ft

Stereochemistry and Global Connectivity: The Legacy of Ernest L. Eliel Volume 2
56 135 Ft
50 522 Ft

Nanomaterials for Biomedicine
77 634 Ft
69 870 Ft

Mycotoxin Prevention and Control in Agriculture ACS
38 220 Ft
34 398 Ft

Frontiers in Molecular Design and Chemical Information Science - Herman Skolnik Award Symposium 2015: Jürgen Bajorath
68 079 Ft
61 271 Ft

The Science and Technology of Silicones and Silicone-Modified Materials
35 353 Ft
31 818 Ft

Food Additives and Packaging
74 051 Ft
66 646 Ft

New Developments in Coatings Technology
35 353 Ft
31 818 Ft